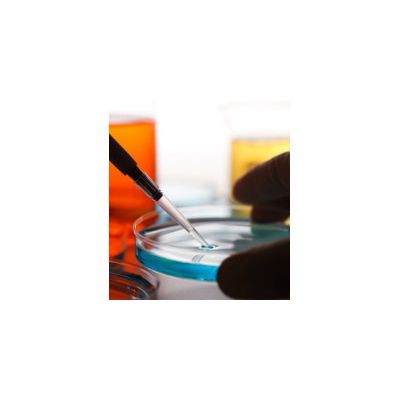

Brodex Water Treatment services
Water Treatments & Central Heating Corrosion Inhibitor Services
Our central heating corrosion inhibitor solutions have saved our customers 1000s of pounds. 45% of heating systems in the UK are not performing efficiently. This can be due to mechanical faults, but most of the time the cause is more worrying and invasive if left untreated. Poor or no water treatments cause destructive corrosion and bacteria growth. This causes system blockages, damage to pumps and even perforation of radiators and pipes. This could be avoided with the simple addition of chemical treatment.
Legionella Risk Assessment & Control Services
Legionella species are the causative agent of the human Legionnaires’ disease. Legionella transmission is via aerosols, the inhalation of mist droplets containing the bacteria.
Tank And Water System Upgrades & Water Tank Replacement Services
Water systems regularly contain areas that may encourage bacteriological growth. At Brodex we can identify these areas and correct a system to help reduce this risk. This may be anything from a tank clean & chlorination or removing pipework dead legs which are very common on some site’s systems. You have a duty to ensure the system is as low risk as reasonably practical to help prevent bacteriological growth and infecting building occupants.
Legionella Testing & Legionella Treatment Services
One requirement of HTM01-05 is that all dental practices have a valid legionella testing program. An expert external assessment is essential for all legionella treatment that might need to be made.